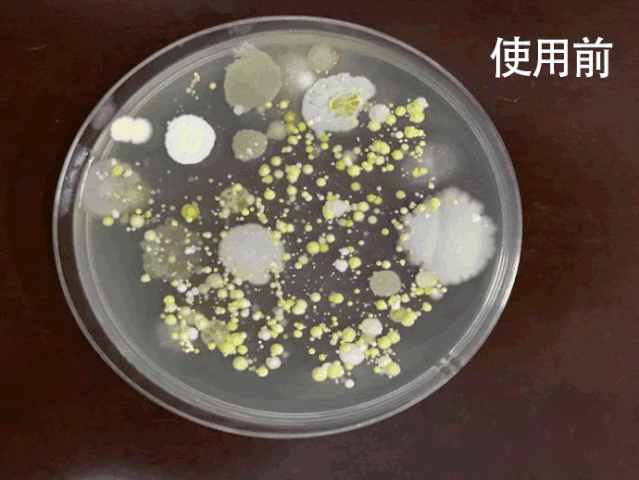

原标题:【消字号认证】仁和消毒湿巾,杀菌消毒、居家出行常备
冬季疫情反复,虽然防控做得严谨,但气温越低,病毒愈发活跃,随着人群的流动和聚集,病毒传播与扩散的风险也在增大。
想想真的是要注意,毕竟——病毒除了能在空气中传播,还能生存在物体上数天。大到公共场合,小到物品包装、门把手,键盘、电梯按钮....甚至是离不开的手机上都会存在病毒。
任何地方都可能是它们“落脚”的地方。

所以防范意识丝毫不能松懈,远离病毒危害,“保护好自己和家人不成为感染源”,才是当务之急。
大家要知道,新型冠状病毒是有弱点的——不耐高温。75%医用酒精和季铵盐,是可以消灭病毒的。
而市面消毒产品真的是不计其数,但是方便好用又能真正达标杀菌的却很少。
现在推荐这款国货品牌、好品质有保障的,杀菌率杠杠的——仁和乙醇杀菌卫生湿巾。


这款消毒湿巾,它里面的成分主要是季铵盐消毒剂,能快速杀死绝大部分的细菌病毒,防疫路上有它真的很安心!
特殊时期,随身携带杀菌产品真的真的很有必要的!


而且品牌方也没有提高价格,还做了优惠力度,可以说是很良心了!
由于特殊时期,物资较缺,本品不支持退换!趁快递还没停运前,建议大家多囤包。拍一发三(3大包)共180片49元,当天发货!当天发货!当天发货!注:不会操作微信购物的读者,可拉至本文底部,添加客服微信好友,联系客服帮您下单。
点击下方图片进行购买
49元 得 3包
3大包共180片
【拍一发三】
01
专业消字号产品
让你远离细菌病毒
市面上的所谓的消毒湿巾鱼龙混杂,甚至有不少假冒伪劣产品,以次充好。
专家提醒,大家在选择时,一定要认准消字号,这样才能保证有消毒效果。
这款消毒湿巾,获得国家“消字号”认证,用它消毒很安心。

根据专业机构检测,它能杀灭多种细菌。可以杀灭肠道致病菌、金黄色葡萄球菌、白色念珠菌、霉菌等常见病菌。
实实在在的杀菌效果,品质好,杀菌率高,安心可靠。
之前的研究表明,病毒的潜伏期可达24天!大家无论是在家还是在外,都不能掉以轻心。

加上现在也是流感病毒、手足口病的高发期,要做好消毒,免得在这时候得病频繁跑医院。
- 外出买菜、拿快递外卖后,回家先擦擦手手;
- 饭前便后擦擦手;
- 工作时擦电脑和手机,小孩玩具甚至是电梯按钮和门把手也可以用它擦。

02
复合配方,双重杀菌
一擦杀灭多种菌
很多人以为酒精可以消毒,就直接在家喷酒精,这样很危险!
居家使用应该小心,酒精易燃甚至爆炸!

还有人把酒精直接涂手上,结果把手弄伤了。

而且坐地铁/飞机等等,液体酒精都基本是违禁品。
这款消毒湿巾的亮点在于——复合配方:医用酒精+苯扎氯铵,双重杀菌更有效率。

医用酒精的厉害的杀菌效果,就不用多说了。
为了杀菌效果,仁和乙醇杀菌卫生湿巾还特别添加了0.2-0.3%的复合双链氯季铵盐类。
专业人士也表明:苯扎氯铵(氯季铵盐类)消毒剂更安全、有用。它能吸附病菌体,产生室阻效应,让病菌生长受抑而死。
在很多地方都能看见,大家用它作为优选消毒剂的身影。
所以,我们普通人用它消毒,也是没有问题的。
相比高浓度的酒精产品来说,更推荐这款消毒湿巾,家里有老人跟小孩的可以安心用。
这款消毒湿巾在成分上除了采用复合配方杀菌之外,还加入了7级过滤的EDI纯水。

这种纯水本身也是有物理杀菌的效果的。
这款酒精湿巾还特别贴心的添加了滋润成分,湿度适中,不仅可以杀菌,擦完手后不会拔干更滋润了。

注:不会操作微信购物的读者,可拉至本文底部,添加客服微信好友,联系客服帮您下单。
点击下方图片进行购买
49元 得 3包
3大包共180片
【拍一发三】
03
免洗速干,安心杀菌
柔和不伤肤
对于湿巾来说,面料也十分重要。
有不少湿巾,用的原材料不够好,动不动起絮、还一撕就烂,擦拭体验一言难尽。

而且会添加很多化学成分,使用后直接残留在皮肤表面。

而仁和乙醇杀菌卫生湿巾的每一张湿巾,除了质量特别抗打,也没有什么特别的添加物。


甲醛、荧光剂,也都经过检验测试:

香精、漂白剂的问题也无需担心,小朋友都可以放心使用。

特殊时期出门,或是家中有孩子、宠物,可以在家多囤一些。

家中、办公室、车里各备一包,以防不时之需,还可以带上高铁。
更何况,它真的是日常生活中的刚需,除了擦手,还能擦物品。

04
仁和出品
品质保证,品牌值得信赖
单听仁和这个名字,你一定觉得不陌生,在我国药品企业中,仁和也算是比较知名了,在前几年的电视时代时,也见过不少他们的广告。

这款乙醇杀菌卫生湿巾就是仁和的主推产品。
全部采用药品级原料及药品级无菌生产车间~

采用铝膜保险术,锁住水分,防止变质,使用后密封闭合,避免外界污染,久放水分也不会被蒸发。

在安全性上自然不用多说,成分含量都让你放心。
平时家里的门把上或者宝宝的玩具、购物袋、共享设备上等等都可以用它来擦拭。
还是要给大家啰嗦一下,在疫情当前大家一定要注意个人卫生情况。
平时小小的动作就可以轻松隔离病菌伤害,为什么不做呢?
拍一发三(3大包)共180片49元,趁快递还没停运前,建议大家多囤包。现货不多!大家可以看着个人情况和需要购买。注:不会操作微信购物的读者,可拉至本文底部,添加客服微信好友,联系客服帮您下单。
点击下方图片进行购买
49元 得 3包
3大包共180片
【拍一发三】
联系客服
长按下方图片
添加客服微信好友
↓↓↓


